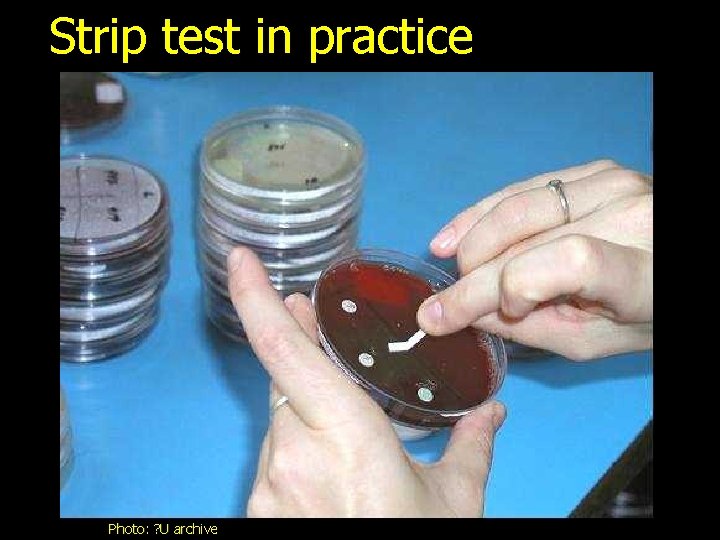
Strip test in practice Photo: ? U archive

Searching for microbes Part III Identification methods mostly

Searching for microbes Part III. Identification methods (mostly biochemical) Ondřej Zahradníček To practical for VLLM 0421 c Contacts to me: zahradnicek@fnusa. cz

Survey of parts of this slide show A tale for introduction Identification methods – global principles Identification methods – problems & solutions Identification methods – not based on substrates Identification methods – practical approaches (details inside) New approaches in identification methods Check-up questions

Tale • Once a sick student told to his sister: I have borrowed some things from my school mates, and now I have to give them back. But I am sick. Would you be so kind and go and give things to them? • Microbiological textbook belongs to Peter. He has blue eyes and blonde hair. • Coloured pencils belong to Ahmed. He has brown eyes and black hair. • The photograph of Britney Spears belongs to John. He has brown eyes and blonde hair.

The sister knew now: • It is not possible to use eye color only to identify her brother mates. • It is also not possible to use hair color only to identify them. • It is necessary to use combination of both. Eyes Peter blue Ahmed brown John brown Hair blonde black blonde

Remember: • If the sister would meet a monster, half. John, half-Ahmed, she would not be able to identify it. • We require pure strains of bacteria to be able to identify them. It is not possible to work with mixtures of bacteria!

Identification methods – global principles

Position of the method in system • Direct methods (microbe – part – product): – – Microscopy – both detection in specimen and identification Cultivation – both detection in specimen and identification (Biochemical) identification – identification only! Antigen detection – both detection in specimen and identification – Nucleic acid detection – usually only detection in specimen – Animal experiment – usually only detection in specimen • Direct methods (antibodies)

Differences in metabolism of various bacterial genera and species • It is big difference, whether bacteria perform fermentation or aerobic respiration • It is a difference, whether bacteria breakdown rather proteins and aminoacids (e. g. genus Proteus) or rather sugars (e. g. genus Klebsiella) Breakdown of a certain substrate is often a sign of adaptation to a certain environment (well adapted enterobacteria download lactose, that they find in our intestine)

General principle I • Bacteria have their specific metabolism • Industrial microbiology exploits bacterial metabolism (mostly fermentative catabolism) to production various stuff, including a lot of food • Medical microbiology exploits differences in metabolism between various bacteria • Inter-species differences interest us here. Differences between individual strains of the same species are rather a complication

General principle II • We offer certain substrate to a bacterium, and we search, whether bacteria change it into product(s) using an enzyme. At least one of products has to be different from substrate by physical phase or color. If it is not different, we use an indicator • There a lot of ways technical form of this test type. Even between mammals there are differences. Human body is not able to produce vitamin C, body of some mammals is.

To review… Do you know, that you have already met such a biochemical test? No? But yes, at cultivation! It is ENDO AGAR There is a biochemical test in it: it differenciates bacteria into lactose positive, and lactose negative species. Photo O. Z.

Identification methods – problems & solutions

Problems • There also differences between strains of the same species, not only between species • Rarely we can see, that 100 % or 0 % strains of a certain species produce a given enzyme • More often it is 90 %, 10 %, 70 %, 30 %… • How it can be in practice: Avinella produces joanellase in 90 % cases Saantella produces joanellase in 10 % cases Joanase positive microbe can be: a typical Avinella, but also an atypical Saantella

Problems – solution • If we search for one atribute only, is big probability, that we will meet an atypical strain and identification will be false • Nevertheless, it is very small probability, that a strain would behave atypically e. g. in ten various tests in the same time • Therefore the more tests, the bigger reliability of such a testing • More tests also enable us to detect more different genera and species

Probability of the result • As we have said, the more tests we use, the better chance that we are not mistaken we have • Nevertheless, that chance is never entire 100 % • It is possible to say e. g. , that our hypothetical strain is – for 99. 3 % Avinella elegans – for 0. 5 % Saantella pulcherima – for 0. 2 % something different • It is on decision of identificator, whether such a probability ratio is enough, or other discrimination tests are necessary

Not only percent of probability, but also typicity index of a strain • In reality biochemical identification result is usually characterized by two numbers, not just one: – % probability: e. g. there is 90% probability, that strain really is Avinella elegans and not something other – Typicity Index: ratio of identity with an „ideal strain“ of Avinella elegans. When a strain is ideal, Tin = 1. 00; when strain e. g. does not produce joannase, although 90 % of Avinella strains produce it, Tin will be less than 1. 00

Examples • A strain has identification 99 %, typicity index 0. 95. Ideal situation, probably „is to that“. • A strain has identification 99 %, but typicity index only 0. 63. It might be an atypical strain (is good to know, what is the „test against the identification“), but also a diagnostic mistake • The typicity index is 1. 00 for two different strains, percent of probability is 49. 5 % for each of them (one percent of remains to „other“). It means, that it is nearly certain that it is one of them, but without discrimination tests we do not find, which one is it.

Identification methods – practical approaches

Practical ways of doing it • Quick tests (seconds to minutes) – Catalase test – Tests with strips (oxidase) Testdiagnostic with diagnostic strips • Tests with incubation (hours to days) Simple test tube tests – Simple test-tube tests – Complex test-tube tests – Sests test-tube tests Sestsofofsimple/complex test tube tests – Tests in. Test microtitration plate in microtitration plates – Other tests (e. g. Švejcar's plate)

Catalase test • Catalase test: very simple: we mix bacteria with substrate (H 2 O 2 solution). Bubbles = positivity. Principle: 2 H 2 O 2 2 H 2 O + O 2 • Some examples of practical use: medic. med. uth. tmc. edu/path/oxidase. htm

Practical note • The recommended way how to perform the catalase test is to make a drop of hydrogen peroxide on a slide and to mix the strain with it • Some microbiologists make a drop directly to the agar. In case of blood agar, this is risky – microbiologists should be experienced to distinguish between true catalase reaction of bacteria and week catalase reaction of red blood cells • In practical sessions, do not use this form also for another reason: the H 2 O 2 kills the bacteria and so no living bacteria would remain for other students

Tests with diagnostic strips • Tests with dg. strips – We touch colonies by reaction area. If positive, the area changes its color. The more common are: –oxidase – reaction area becomes blue (or at least the spots where we touched the colonies). For examples of use of oxidase test, click on „ “. –INAC – reaction area after several minutes becomes blue-green; the strip should be moistened before being used –PYR – reaction area after 5– 10 minutes, addition of a reagent and one more minute of waiting becomes red –betalactamase strip – testing of some resistance factors (more in J 06)
Strip test in practice Photo: ? U archive

Oxidase test medic. med. uth. tmc. edu/path/oxidase. htm

Simple test-tube tests They may be in liquid phase, or in agar. In both cases, substrate is in a test tube, eventually together with an indicator. Examples of technical details – see following slides

Simple test tube tests – I • 1) The substrate is diluted in the liquid, during the test a strain is mixed with the liquid, after incubation we observe change of color (in whole volume, or as a ring at the surface). Example: Arabinose test for differenciation of streptococci (liquid remains green = test negative, Enterococcus faecalis; liquid turns to yellow = test positive, Enterococcus faecium)

Simple test tube tests – II • 2) Firstly, the strain is mixed with a liquid (physiological saline). Then a strip (similar to oxidase strip) is added. The strip area contains substrate. Substrate is released from reaction area. Example: ONPG test (positive = fluid becomes yellow, negative = fluid remains colorless), VPT (after addition of two different reagent in negative case nothing changes, in positive case a red ring at the surface is formed)

ONPG test • ONPG: An example of a simple test-tube test. The substrate is poured to a test-tube and a strip is added. When the fluid turns yellow, it means test positivity. Example of use: differentiation between Citrobacter (positive) and Salmonella (negative)

Simple test tube tests – III • 3) An agar is prepared containing substrate. The color either remains original, or is changed. Example: Simmons citrate. When the medium remains green, it is negative, when it becomes blue, it is positive. medic. med. uth. tmc. edu

Complex test-tube tests • In one test-tube we have more reactions • For example MIU test: – M = motility (turbidity is spread through a half-liquid agar, not only in site of inoculation) – I = indol (positivity = red ring) – U = urea (breakdown of urea is indicated by the whole medium turning pink) • Or Hajna medium

www. arches. uga. edu MIU could be also done as three individual tests: motility…

…indol and urea medic. med. uth. tmc. edu

Hajna medium (Kligler Iron Agar – KIA in Hajna modification) • • • Color of the bottom part of the medium unchanged: bacterium does not ferment glucose (differenciation of so named G- non-fermenters × enterobacteria) Bottom part turns black – formation of H 2 S Broken medium, with bubbles – gas formed from glucose Bottom part yellow, upper part red – bacterium is a glucose fermenter, lactose non fermenter The whole medium is yellow – lactose fermented, too www 2. ac-lyon. fr/

Example of conclusion of Hajna + MIU Test Reaction Pseudomonas aeruginosa Escherichia coli Proteus mirabilis Salmonella enterica Citrobacter freundi Hajna MIU Glc Lac H 2 S Mot Ind Ure - - - + + + + - - + + (+) + - -

Sets of test-tubes • Complex test-tube tests have some problems. Often positivity of one test disables to see another one. It is difficult to authomatize them and they require experienced personel. • More simple, although sometimes more expensive solution, is a set of several simple test-tube tests • It is, of course, also possible to combine both simple and complex tests (e. g. Hajna + MIU + Simmons citrate + ornithin dekarboxylase – in our laboratory)

Miniaturisation: tests in microtitration plates • Miniaturisation of a simple test-tube tests set tests in microtitration plate wells. Each test-tube is replaced by a well. • Number of tests in sets is variable from seven (Neisseria Test) to more than fifty • Technical detail are various. Nevertheless, always the substrate is dried, bacteria are mixed with saline of suspension medium and then it is mixed with the dried substrate

Tests by Erba Lachema (most common in Czechia) • The factory produces plates with dried substrates, placed in the bottom of the wells • We prepare a bacterial suspension in saline or suspension medium • To each well we add one or two suspension drops • The remainder of suspension is often used as test tube test with a diagnostic strip (ONPG, VPT) • Both the plate and the test tube is incubated in a thermostat

NEFERMtest 24 Erba Lachema: one frame enables testing of four triple-strips (four tests, determination of four various strains) Photo: O. Z.

Other producers www. ilexmedical. com/products_engl/api. htm. (the same principle, small differences in practical form) Foto: O. Z. http: //www. oxoid. com/blue Press/uk/en/images/PR 020 505. jpg www. ilexmedical. com/products_engl/api. htm.

www. ucd. ie/kyr/Images/jpgs/Photo 16. htm

Evaluation of plate tests • Such a test gives us a row of results – usually in form of „+“ (test is positive, substrate changed) or „-“ (test negative, substrate unchanged, original color). • An example of a: + - + + + - - - -++++ • There are several ways, how to convert such a row into a „legible result“

Ways of evaluation • Comparison with a table is possible for simple tests and clear results only. • Conversion into octal codes plus searching result in the code list. Common. • Result input directly into a computer, which gives us the result. Not always practical Computer evaluation is often used when the reading itself is automatic, e. g. on a spectrophotometer.

Octal codes – what is it, and why • Mathematically it is conversion of binary system (+ + – – –, or 11000) into octal system (written 630) • For practical reasons, reading inside triplets is usually reverted – normally 1 1 0 converted into octal code should be six and 0 1 1 three; in our „microbiological re-counting“ is uses to be the opposite

Octal codes – II • In practice, each triplet of result is converted into a number 0 to 7. • Of course, when a test has e. g. 17 reactions, there is a pair instead of triplet at the end (so the final number can be only 0, 1, 2, 3). • When we have e. g. 16 (19, 22…) reactions, the final number should be zero or one only.

Practical example • We mark positive and negative reaction results • Under each triplet we write 1 – 2 – 4 • For each triplet we read only „+“ numbers, not „ –“ (these go out) Test Result Code JAN LEN MAG TOM PET KAR FRA HAN + 1 – 2 5 + 4 + 1 + 2 3 – 4 – 1 – 2 0

Re-counting the triplets ––– +–– –+– ++– ––+ +–+ –++ +++ 124 124 1 2 1 4 1 2 1 +2 +4 +4 +2+4 0 1 2 3 4 5 6 7

For example, in ENTEROtest 16 (17 tests) ONPG 1 2 H 3 G 4 F 5 E 6 D 7 C 8 B 9 A 10 11 12 13 14 15 16 17 H G F E D C B A First row of the plate 2 nd row of the plate +S llllllll – S llllllllllllllll ? + – + + + – – – – + + 1 2 4 1 2 4 1 2 5 3 0 0 6 3

Identification methods – not based on substrates

Other identification tests • Besides tests based on substrate breakdown, we have also other similar tests, that find presence of some bacterial enzymes or virulence factors. For example: – Test of ability to coagulate rabbit plasma – Test of ability to agglutinate rabbit plasma – Test of ability to decapsulate an encapsulated strain (hyaluronidase test) – Motility testing – we have had it already

Plasmacoagulase and hyaluronidase (both tests are used in staphylococci) www. hardydiagnostics. com Photo O. Z.

Diagnostic use of antibiotics • One possibility is also in vitro susceptibility testing to a certain antibiotic in situation, that we know, that strain X is in 100 % susceptible and strain Y is in 100 % resistant. In practice, it is, of course, never 100 %. • An example is optochin test • Practically it the same as normal antibiotic susceptibility tests, see the practical two weeks later

Optochin test negative and positive http: //www. mc. maricopa. edu

New approaches in identification methods

New identification methods • One of trends of recent period is automatisation of biochemic identification at use of an expert system. Sometimes it is directly bound to (automatic) cultivation. • Problem at using these methods is that usually the clinical origin of the strain is not taken into account sufficiently, and so the preciseness of identification, choice of probable pathoten × accidentally contamining strain etc. is not always suitable. • Another approach give us new methods on new principles, e. g. mass spectrometry type MALDI-TOF, see further

MALDI TOF • Principle: mass spectrometry – already long time used in chemistry, but classic ways only enabled detection of small molecules – Based on division of ionised particles according to their molecular mass – now ionisation by laser enables to detect also large molecules, charakteristic for individual species of bacteria/yeasts – uses ionisation by laser at presence of a matrix (MALDI, matrix assisted laser desorption/ionization) in combination with time of flight detector (TOF, time-of-flight) • Recently very expensive (6 000 CZK) • In Czechia in several places now (temporarily at our institute – only I–III/2011)

MALDI TOF – details • Speed of the particle (connected with its mass) may be counted from detected time of flight (TOF) • Mixture of matrix (4 -hydroxy-cinamic acid) and specimen on the metalic plate is beaten by a nanosecond laser pulse • matrix absorbs the energy of the pulse and molecules of the specimen are ionised by its jejím fragmentation • Method „finds“ specific proteins of the strains and compares them with the databese, today already pretty large, but still enlarged

MALDI-TOF Link to producer‘s websites

Work with MALDI-TOF

Preparing strain for MALDI-TOF

The End http: //www. telmeds. org

Examples of catalase test use • The most common use it in diagnostics of G+ cocci. Among medically important genera, staphylococci are catalase +, while streptococci and enterococci are catalase – • Nevertheless, there exist some more examples, too, e. g. in G+ rods: Listeria is catalase +, Erysipelothrix (microscopically similar) catalase –

Examples of oxidase test use • Oxidase can be used in various situations: • To confirm diagnostics of Neisseria, Moraxella and Pseudomonas (oxidase positive) • To differentiate between Vibrionaceae (oxidase +) and Enterobacteriaceae (oxidase – except genus Plesiomonas)

Check-up questions Try to find the answers, then answer to the questions in ROPOT. The formulations of questions might be slightly different. 1. What does abbreviation "MIU" mean? 2. Why sometimes even for differentiation of two specimens one test is not sufficient? 3. How do we use the oxidase strip? 4. What is the visible difference between products and substrate in the catalase test? 5. Percent of probability of identification and typicity index: is it the same? 6. There is a certain medium. When we culture bacteria there, we get the information whether they ferment lactose. What is the name of this medium? 7. When we do not need an indicator at biochemical identification reaction? 8. When a saccharide is exploited by a bacterium, does it always mean it fermentation? 9. Is it possible that one organism is able to split certain substrate, and another is not? 10. And also some more surprises
- Slides: 63